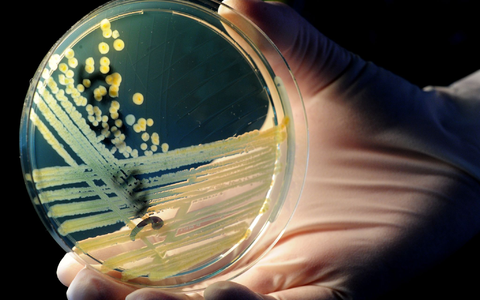
Vom Verzehr eines verunreinigten Lebensmittels bis zum Ausbruch der Erkrankung dauert es im Durchschnitt drei bis vier Tage (Archivbild) - Foto: Julian Stratenschulte/dpa Vom Verzehr eines verunreinigten Lebensmittels bis zum Ausbruch der Erkrankung dauert es im Durchschnitt drei bis vier Tage (Archivbild) - Foto: Julian Stratenschulte/dpa

Thema: Norddeutschland
Berufskraftfahrer-Prüfung, Kabinett

Berufskraftfahrer-Prüfung: Kabinett senkt Zeit auf 120 Minuten - Foto: über boerse-global.de

Berufskraftfahrer-Prüfung: Kabinett senkt Zeit auf 120 Minuten
boerse-global.de, 29.05.26 06:03 Uhr
Betriebsräte-Weiterbildung, Seminare
Neue Seminarzyklen für Betriebs- und Personalräte starten. ...
Betriebsräte-Weiterbildung: Neue Seminare ab Juni 2026 in Norddeutschland
boerse-global.de, 26.05.26 03:24 Uhr
Bornavirus, Norddeutschland
Erster humaner BoDV-1-Fall in Mecklenburg-Vorpommern bestätigt. ...
Bornavirus erreicht Norddeutschland: Erster humaner Fall in Mecklenburg-Vorpommern bestätigt
boerse-global.de, 23.05.26 19:01 Uhr
Schienenverkehr, Norddeutschland
Private Bahnbetreiber warnen vor Insolvenzwelle durch überlastete ...
Schienenverkehr in Norddeutschland: Private Anbieter vor der Insolvenz
boerse-global.de, 22.05.26 22:52 Uhr
Telekom, Aktie
Telekom-Vorstände erwerben planmäßig Aktien während ...
Deutsche Telekom Aktie: Vorstand kauft, Verdi streikt
boerse-global.de, 20.05.26 22:36 Uhr
Vermilion, Energy
Vermilion Energy verdoppelt Explorationsfläche in Norddeutschland. ...
Vermilion Energy Aktie: 1 Million Acres in Deutschland
boerse-global.de, 28.04.26 10:23 Uhr
Apotheken-Protest, Norddeutschland
Tausende Apotheken schließen im Norden Deutschlands aus ...
Apotheken-Protest: Norddeutschland streikt gegen das Sterben
boerse-global.de, 23.03.26 09:34 Uhr
Bundespolizei, Schleuserbande
Bei einer bundesweiten Polizeiaktion wurden mutmaßliche ...
Bundespolizei zerschlägt mutmaßliche Schleuserbande in Norddeutschland
boerse-global.de, 11.03.26 00:00 Uhr
Ehec-Fälle, Vorpommern
Ehec-Fälle in Vorpommern und Belgien hängen nicht zusammen. ...
Wie es zu den steigenden Ehec-Infektionen in Norddeutschland kam, ist noch unklar.
dpa.de, 03.09.25 16:36 Uhr
Bahn-Verspätungen, Störungen
Bahn-Verspätungen nach Störungen und Böschungsbränden. ...





